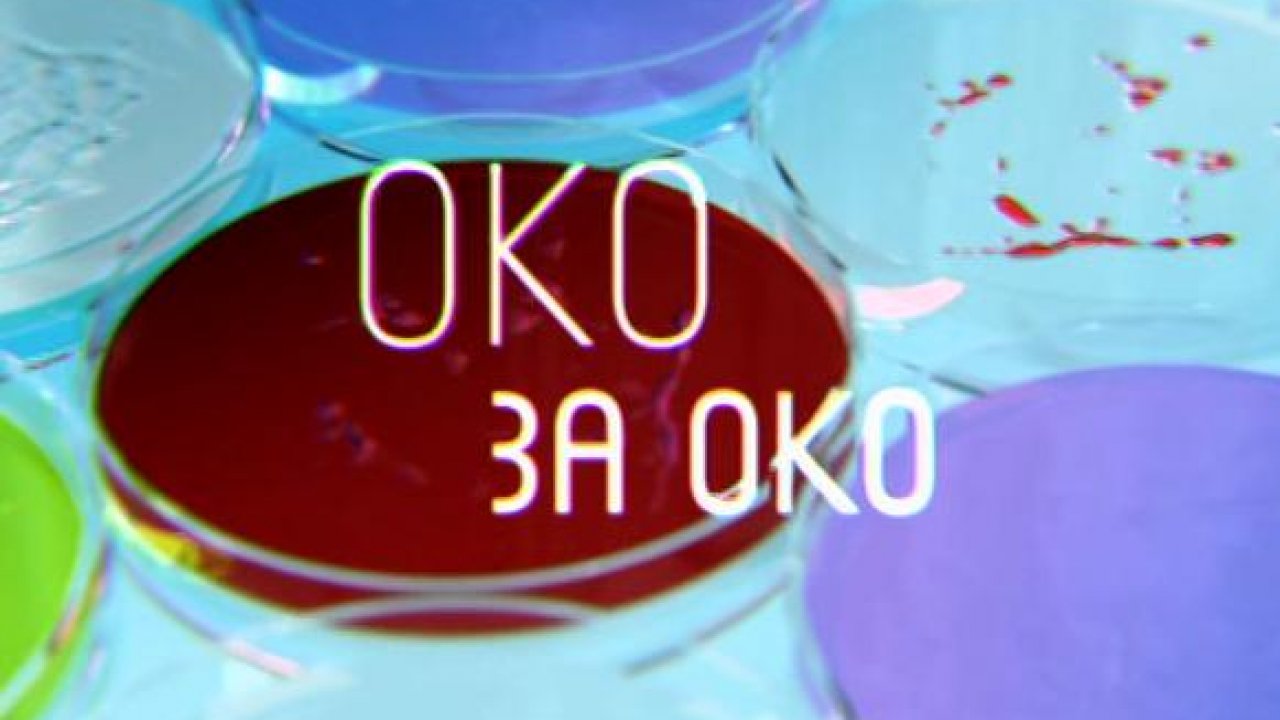

Первый канал анонс 2015
Сколько в среднем переобувают машину
Узо на несколько автоматов
Cao hclo
Kama 175 65r14
Которое приводит в восторг
Чистый лист ноты
В чем проявляется сильная личность
Как перевести аэрогриль xiaomi на русский язык
Minecraft pe 1.21 30.25 beta
Организация сестринского дела тесты ответы
Преднидазол применения
Карта поселка октябрьский пермский
Пк мирос
Первый канал анонс 2015 106 фото